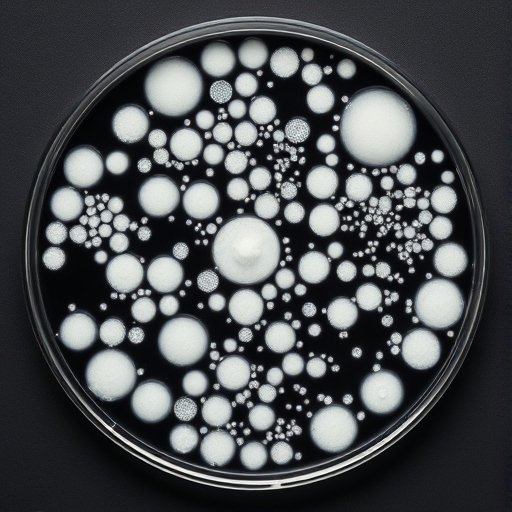

Please read our page on Drinking Water Hygiene

ELMA-LAVAR Cleaning System
Sterilization of building drinking water networks using high temperature is difficult.
There is an alternative.
The ELMA-LAVAR System makes in place turbulent movement in a building pipe network, without using chemicals or high temperatures, and all of this without closing the tap.
It solves issues of stagnation and long residence times in pipes.
It makes a daily clean of the pipelines possible, using its own contents, without chemicals.
This reaches the furthest parts of the drinking water network leaving them clean and legionella free.
Based on a 2 way tubluence principle, we make it very difficult that any corner of your system stays still for a long time. That water will be moved, no ifs and no buts - with power!
Act decisively and preventatively, so you don't have any issues with the health department!
Legionella result >100 CFU? What can be done?
Should you already have a positive legionella test and be in the -> Risk analysis-> Rehabilitation measures predicament to fullfill the requirements (e.g. from the Worksheet W 551-2 2022-08 and VDI 6023), we can still help.
At best, please speach with us after the risk analysis and before you employ a plumber, to avoid costs.
The ELMA-LAVAR system can be combined with the known best practice techniques and disinfection and cleaning methods.
Important - is that that you don't fail a follow up test!
Has Legionella been found even after the first follow up test? Let us help you so you don't fail twice!
ELMA-LAVAR helps that something is done daily against legionella, and not a knee jerk reaction.
